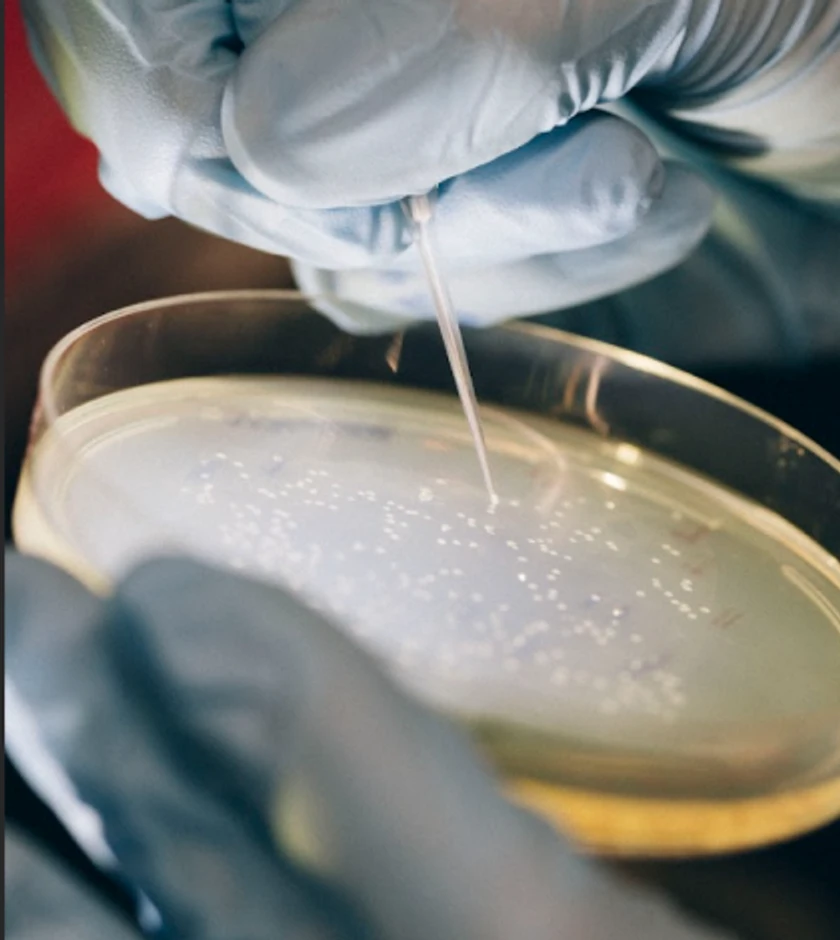

Our Bio-
Manufacturing
Platform
Manufacturing
Platform



STAGE 1
Plant Genetics
PROTEIN
ENGINEERING
Molecular designs are customized for specific target proteins. We select genetic elements to maximize protein accumulation and functionality. We can achieve gene expression, ensuring that the desired proteins are produced efficiently, stably, and in a manner suitable for their intended application.
PLANT
TRANSFORMATION
We use Agrobacterium to insert the DNA of interest into soybeans. Agrobacterium has a unique capability to transfer DNA into plant cells, facilitating the integration of a specific DNA segment (T-DNA) into the plant cell's nuclear genome. Once the T-DNA is integrated into the plant’s nuclear genome, it is transcribed into an mRNA sequence which then, will instruct the plant to produce the desired protein.

STAGE 2
Plant Cultivation and Selection
PLANT CULTIVATION & MONITORING
Once our plants start to regenerate, we move them to our 30,000 sf. greenhouse for cultivation and selection. As the plants grow, we monitor multiple parameters such as irrigation, temperature, lightning intensity and more. Once the plants mature to produce seed pods, they are dried down, threshed and taken to our seed bank.

HIGH-THROUGHPUT SCREENING
As the plants grow, we evaluate them at the genetic level and at the protein level. We only select the plants that yielded the most viable seed candidates to propagate into the next generation.

STAGE 3
Protein Processing
PROTEIN PURIFICATION
Once the seeds are harvested, they go through processing where we separate out our ingredient from other processed by-products, such as oil, okara or white flake. Every component of the soybean, apart from our protein, is utilized in various markets to minimize waste. We have developed proprietary processes for purifying proteins, ranging from nanograms to kilograms.

FORMULATION
Our team of product developers takes learnings from protein functionality to optimize product formulation and performance. We test various ratios of ingredients to optimize for flavor and function of our end products.
